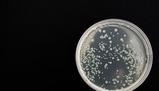

Concetti Chiave
- Le sostanze mutagene sono cancerogene perché causano accumulo di mutazioni in geni chiave, aumentando il rischio di cancro.
- I geni oncosoppressori agiscono come regolatori negativi della proliferazione cellulare, mentre i protoncogeni sono regolatori positivi.
- Le mutazioni cancerogene colpiscono protoncogeni, oncosoppressori e geni di riparazione del DNA.
- Mutazioni nei sistemi di riparazione del DNA possono portare a HNPCC, un tipo di cancro al colon ereditario.
- Le cellule tumorali hanno un vantaggio selettivo grazie alla loro capacità di crescita incontrollata.
Le sostanze mutagene e il rischio
Le sostanze mutagene sono cancerogene perché il processo di trasformazione di una cellula normale in una cellula tumorale consiste nell’accumulo di mutazioni in geni strategici per il controllo della crescita e della divisione cellulare quindi, qualunque agente capace di indurre mutazioni, aumenta il rischio di cancerogenesi.
Regolatori della proliferazione cellulare
Le fasi del ciclo cellulare sono controllate da dei “freni”, sono perciò regolatori negativi della proliferazione cellulare, sono per questo detti oncosoppressori. Esistono però anche regolatori positivi della proliferazione come cicline, l’E2F, fattori di crescita, etc.; questi ultimi fattori sono detti protoncogeni perché se mutati diventano oncogeni.
Classi di geni coinvolti nel cancro
Più in generale le mutazioni che inducono il cancro sono a carico di tre classi di geni:
• protonconcogeni (mutazione attivante/guadagno di funzione);
• oncosoppressori (mutazione disattivante);
• geni coinvolti in sistemi di riparazione del DNA o del MMR (correzione degli appaiamenti errati) (mutazione disattivante). In questo caso viene prodotto HNPCC (cancro al colon ereditario non polipotico).
P.S.: dal momento che una cellula tumorale ha una capacità di crescita incontrollata ha un vantaggio selettivo rispetto alle cellule normali.
Correlazione tra mutazioni e tumori
In sintesi vi è quindi una stretta correlazione tra mutazioni e tumori/cancro, è quindi bene stare attenti.

Accedi a tutti gli appunti
Accedi a tutti gli appunti
 Tutor AI: studia meglio e in meno tempo
Tutor AI: studia meglio e in meno tempo